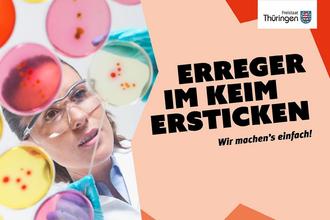

Informationen
Infektionsschutzbelehrung ab 1. März 2025 online möglich
Die Belehrung nach dem Infektionsschutzgesetz, die bei einer Tätigkeit mit Lebensmitteln Pflicht ist, kann ab 1. März 2025 im Landkreis Schmalkalden-Meiningen online absolviert werden. Wer Lebensmittel herstellt, behandelt oder in Verkehr bringt, muss vor Beginn der Tätigkeit eine Bescheinigung des Gesundheitsamtes über die Teilnahme an einer Belehrung nach § 42 und § 43 des Infektionsschutzgesetzes vorweisen, die nicht älter als drei Monate ist. Ziel der Belehrung ist es, Symptome von Infektionskrankheiten oder Symptome von Mitarbeitenden frühzeitig zu erkennen und die Weiterverbreitung sowie Kontamination von Lebensmitteln zu verhindern.
Bürgerfreundlicher Service
„Der Fachdienst Gesundheit ist froh, Infektionsschutzbelehrungen ab sofort auf einer Internet-Plattform anbieten zu können. Hiermit haben wir einen extrem bürgerfreundlichen Service eingerichtet. Auch die Durchführung in verschiedenen Sprachen ist ein großer Vorteil gegenüber der persönlichen Belehrung im Gesundheitsamt“ führt Verwaltungsleiter Alexander Höft aus.
Die Online Schulungen werden montags bis freitags von 8 bis 20:30 Uhr und samstags von 9 bis 15:30 Uhr angeboten. Die Belehrung ist kostenpflichtig. Entsprechende Informationen können hierzu der Anmeldeseite entnommen werden. Als Zahlungsmöglichkeiten stehen Giropay, Kreditkarte, Paypal sowie Überweisung per Vorkasse zur Verfügung.
Mehrsprachige Belehrung möglich
Die digitalen Belehrungsvideos stehen in Arabisch, Deutsch inkl. Gebärdensprache, Englisch, Farsi, Polnisch, Rumänisch, Russisch und Ukrainisch zur Verfügung. In weiteren Sprachen kann das Video mit Untertitel abgerufen werden. Nach der Belehrung ist die Teilnahme an einem Test verpflichtend. Wurde dieser erfolgreich absolviert, können Teilnehmer ihr Schulungszertifikat sofort abrufen.
Ergänzend zur Onlinebelehrung finden weiterhin Präsenzveranstaltungen in den Räumlichkeiten des Landratsamtes in Meiningen statt. Nähere Informationen zu Infektionsschutzbelehrungen und die Möglichkeit der Anmeldung zur Präsenzveranstaltung sind auf der Seite des Landratsamtes Schmalkalden-Meiningen unter Terminbuchung https://termin.lra-sm.de im Abschnitt Fachdienst Gesundheit abrufbar.
Für Fragen rund um das Thema Infektionsschutzbelehrung kann gern das Servicetelefon vom Fachdienst Gesundheit unter Tel. 03693/485 4000 kontaktiert werden.
Schulung für Schüler weiterhin in Präsenz notwendig
Für Schülerinnen und Schüler besteht weiterhin nur die Möglichkeit, über Präsenzveranstaltungen die Infektionsschutzbelehrung durchzuführen.
Bei einem Schülerpraktikum wird darum gebeten, sich bitte unter der Tel.: 03693/485 8702 oder per E-Mail an belehrung@lra-sm.de zu melden.
Weitere Informationen zum Thema Praktikum sind über diesen QR-Code nachzulesen: